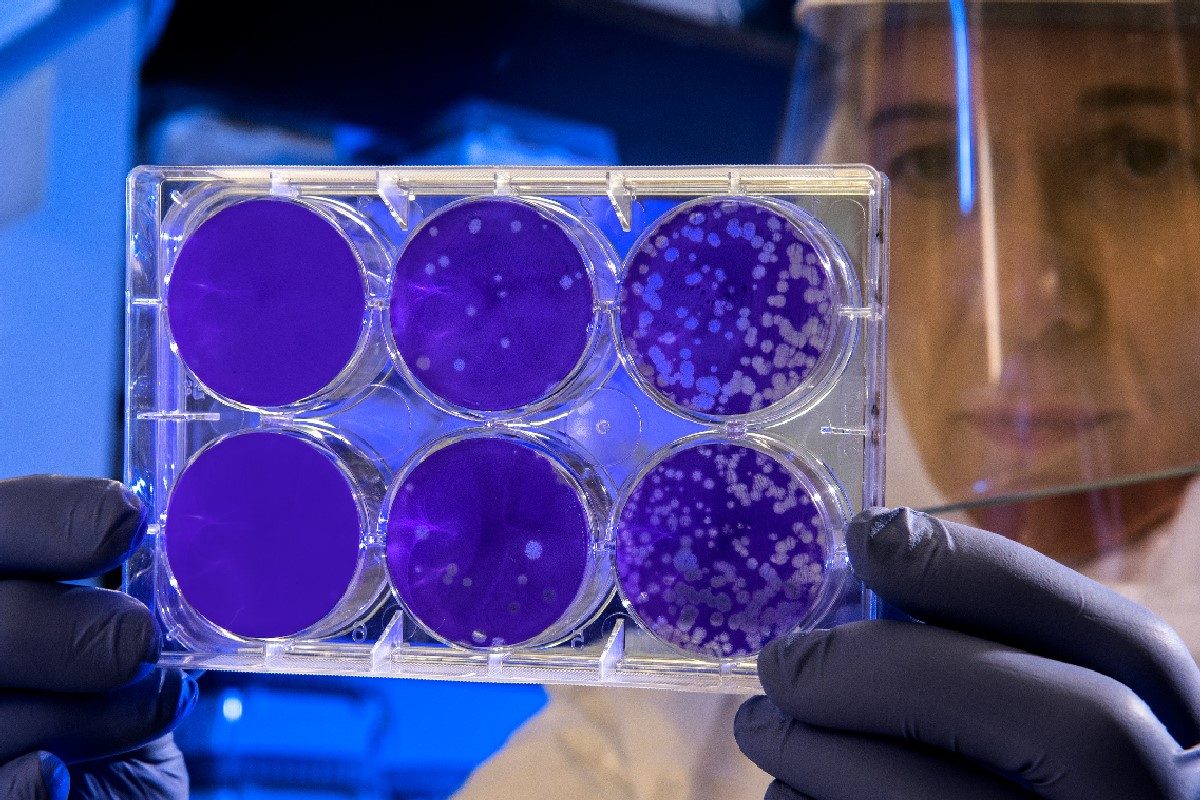

O nouă boală neidentificată îngrijorează lumea medicală. Cel puțin 50 de oameni au murit într-o țară africană, iar evoluția simptomelor i-a alertat pe experții de la Organizația Mondială a Sănătății (OMS).
O boală necunoscută a ucis peste 50 de persoane în nord-vestul Congo-ului, potrivit medicilor de la fața locului și a Organizației Mondiale a Sănătății (OMS).
Boala misterioasă aduce moartea în 48 de ore
Intervalul dintre debutul simptomelor și deces a fost de doar 48 de ore în majoritatea cazurilor și "acesta este cu adevărat îngrijorător”, a declarat Serge Ngalebato, directorul medical al Spitalului Bikoro, pentru Associated Press.
Focarul din orașul Boloko a început după ce trei copii au mâncat un liliac și au murit în 48 de ore în urma simptomelor de febră hemoragică.
Temerile lumii medicale cu privire la bolile care se răspândesc de la animale la oameni sunt tot mai mari, conform Africa News.
Aceste focare apar în locurile în care animalele sălbatice sunt consumate în mod obișnuit, însă, din 2022, numărul de astfel de focare a crescut în Africa cu mai mult de 60%.
Boala misterioasă a apărut în orașul Bomate pe 9 februarie, probe din 13 cazuri au fost trimise la Institutul Național de Cercetare Biomedicală din capitala Congo, Kinshasa, pentru testare, a spus OMS.
Toate probele au fost negative pentru Ebola sau alte boli comune de febră hemoragică, cum ar fi boala Marburg. Unii au fost testați pozitiv pentru malarie, arată sursa citată.